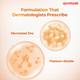
La Shield FISICO SPF 50+ & PA+++ Matte Sunscreen Gel 50 gm - Face Sunscreen

Netmeds First Membership
Description
Introducing La Shield FISICO SPF 50 & PA Transparent Matte Sunscreen Gel - your ultimate defense against the harmful effects of the sun. This innovative sunscreen provides broad-spectrum prote...Read More
Key Benefits
High Sun Protection: Boasting SPF 50 and PA ratings, La Shield FISICO offers superior sun protection to shield your skin against the harmful effects of UV rays.
Transparent Matte Finish: Th... Read More
Direction for Use/Dosage
Start with a clean face before applying sunscreen.
Mix an adequate amount of La Shield FISICO evenly on your face and exposed skin areas.
For extended sun exposure, reapply every 2 hours or more... Read More
Safety Information/Precaution
For external use only.
Prevent contact with eyes; in case of contact, wash well with water.
Discontinue use if irritation or rash develops.
Other Information
Store it in a cool, dry place.
For safety concerns, keep it out of reach of children.